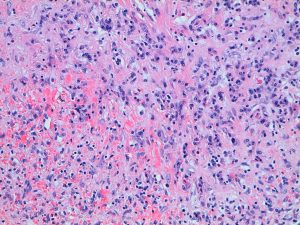

NOTA CIENTÍFICA:
TRANSFORMACIÓN NODULAR ANGIOMATOSA ESCLEROSANTE ESPLÉNICA (SANT). A PROPÓSITO DE UN CASO
Vicente Herrera1, Paloma Garaulet1, Elena Sierra2, Laura Reyes3, Ignacio Rodríguez1.
Servicios de 1Cirugía General y del Aparato Digestivo, 2Radiología y 3Anatomía Patológica, Hospital Universitario Infanta Cristina, Parla, Madrid, España.
Correspondencia: para contactar con el autor accionar aquí.
Rev Acircal. 2020; 7 (2): 74-81.
Palabras clave: Transformación nodular angiomatosa esclerosante esplénica. SANT. Proliferación vascular. Bazo. Esplenectomía laparoscópica.
Descargar artículo en PDF
Introducción:
La transformación nodular angiomatosa esclerosante esplénica, también llamada SANT, fue descrita por primera vez en 2004 por Martel (1,2). Es una infrecuente lesión vascular benigna del bazo de la que se han publicado poco más de 100 casos, caracterizada por la presencia predominante de nódulos angiomatosos en la pulpa roja esplénica.
La etiopatogenia es desconocida pero los nódulos angiomatosos típicos encontrados se consideran una transformación en respuesta a una excesiva proliferación de tipo policlonal del estroma reactiva a otras enfermedades; o bien una forma evolutiva avanzada de lesiones benignas del tipo de los hamartomas, los hemangiomas o el pseudotumor inflamatorio. El virus de Epstein Barr se ha descrito como posible agente causal, tanto en la SANT como en el pseudotumor inflamatorio (3,4). También hay estudios que sugieren que pueda desarrollarse a partir de un daño o insuficiencia vascular generándose una proliferación vascular alterada durante la reacción de curación subsecuente (5).
Afecta de preferencia a la mujer y generalmente es un proceso asintomático siendo por tanto un hallazgo incidental en estudios por imágenes en muchos casos. El tratamiento indicado es la esplenectomía porque las imágenes no son concluyentes para el diagnóstico y pueden corresponder o no diferenciarse de una lesión benigna o incluso de un angiosarcoma o una metástasis; por lo que el diagnóstico definitivo lo proporciona solo el estudio anatomopatológico (5). La biopsia percutánea en ese sentido no está indicada, por el riesgo de complicaciones como el sangrado y la posibilidad de implantes en el trayecto de punción si se tratara de una neoplasia.
Presentamos un caso de SANT tratado mediante esplenectomía laparoscópica mediante tres trócares.
Caso clínico:
Paciente varón de 46 años con antecedentes de espondilitis anquilosante HLAB27+ y nefropatía crónica hipertensiva/tóxica, que acude a la consulta por dolor abdominal continuo en hipocondrio izquierdo de tipo opresivo de unos dos meses de evolución. A través de una ecografía se descubre una lesión esplénica de 50x60mm compatible con hemangioma. En la analítica se apreciaba leve aumento de urea y creatinina siendo el resto de los valores normales. Se completan estudios con TC y RMN (ver Figura 1) que fue informada como una masa sólida de 48x50x43mm, de baja intensidad de señal, heterogénea en secuencia T2, con múltiples imágenes lineales, sin restricción de la difusión y con captación progresivamente mayor hasta las fases más tardías del estudio, permaneciendo una región central hipocaptante. Estas imágenes eran compatibles con hemangioma vs otra lesión de estirpe vascular esplénica sin poder descartar otras posibilidades. El resto del estudio fue normal, sin adenopatías ni ascitis.
Se decidió cirugía por tratarse de una lesión sintomática y no poder descartar malignidad. Se efectuó esplenectomía total laparoscópica con tres trócares sin incidencias, con un tiempo quirúrgico de 160 minutos. Se usaron clips metálicos grandes y sellador de vasos Ligasure de 5 mm para el control de los pedículos. La pieza se extrajo por ampliación de una de las incisiones protegida en una bolsa de extracción laparoscópica y no se dejó drenaje en cavidad. Se dio el alta el 6º día postoperatorio sin complicaciones relevantes y con indicación de vacunación para meningococo, neumococo, haemophilus influenzae; y de profilaxis antitrombótica durante un mes para prevención de enfermedad tromboembólica venosa y trombosis del eje portal.

Figura 1. RMN: se aprecia lesión esplénica, sólida de aspecto heterogéneo.
El informe histopatológico fue: macroscópicamente se aprecia parénquima esplénico de arquitectura alterada por la presencia de una lesión sólida, de contorno polilobulado e irregular; presenta áreas de aspecto hemorrágico y una zona central de aspecto cicatricial, blanquecina y la consistencia al corte era firme y elástica (ver Figura 2). Desde el punto de vista microscópico, la lesión corresponde a una proliferación de pequeños vasos con expresión inmunohistoquímica para CD34 y CD31 en un estroma densamente fibroso, con un contorno lobulado irregular, no encapsulado pero expansivo, que no contacta con los márgenes de resección (ver Figura 3). En conclusión: pieza de esplenectomía con lesión de transformación nodular angiomatosa esclerosante.
El paciente continúa asintomático tras 31 meses de la cirugía y ha sido dado de alta sin tratamiento de la consulta de hematología donde se despistaron otros focos neoplásicos con los estudios de imagen correspondientes.

Figura 2. Pieza quirúrgica esplenectomía abierta para ver la lesión tipo SANT y su consistencia.
Figura 3. Aspecto microscópico: nódulos compuestos por una proliferación de estructuras vasculares con infiltrado inflamatorio de tipo mixto.
Discusión:
Los tumores primarios más frecuentes del bazo son lesiones vasculares del tipo de los hemangiomas, hemangioendoteliomas, tumores de células litorales; y entre ellos se debe tener en cuenta una entidad descrita recientemente, la transformación nodular angiomatosa esclerosante. Se trata de una lesión vascular no neoplásica que es difícil de diagnosticar preoperatoriamente (6).
Los pacientes con el diagnóstico de SANT son especialmente mujeres de alrededor de 50 años, en relación 2:1. Se trata probablemente de una lesión tisular reactiva dado que es frecuente que coexista con otras enfermedades inflamatorias y neoplásicas (7,8).
Es una patología infrecuente, benigna, de pronóstico excelente, asociada en ocasiones (hasta 23.6%) a enfermedades, principalmente neoplasias como cáncer hepato-bilio-pancreático, de pulmón, mielofibrosis idiopática, pielonefritis, etc. (7) y a enfermedad relacionada con IgG 4 (9). La mayoría de los pacientes son asintomáticos y su hallazgo incidental, pero puede asociarse a dolor, esplenomegalia, leucocitosis, anemia, gammapatía monoclonal y aumento de la VSG (10,11,12).
El diagnóstico se confirma por el estudio anatomopatológico e inmunohistoquímico. Podría efectuarse mediante biopsia percutánea pero dado el alto riesgo de complicaciones es preferible la resección quirúrgica. Como diagnósticos diferenciales se incluyen tumores benignos vasculares, el angiosarcoma, linfomas, el pseudotumor inflamatorio y las metástasis esplénicas.
Desde el punto de vista histopatológico, la SANT muestra Infiltrados linfoplasmocitarios, estroma fibromixoide y nódulos angiomatoides en la pulpa roja esplénica. El estudio inmunohistoquímico de estos nódulos muestra 3 tipos de estructuras vasculares: capilares (CD34+/CD31+/CD8−), vénulas (CD34−/CD31+/CD8−) y sinusoides (CD34−/CD31+/CD8+) (13).
Ante un caso como el que se presenta el dilema es si se trata de un proceso benigno o neoplásico y que muy probablemente no se pueda confirmar antes del estudio histopatológico diferido. El tratamiento de elección es la esplenectomía, en lo posible parcial con biopsia intraoperatoria del borde (14). Esto permite preservar la función inmunológica y evitar la sepsis postoperatoria. Para ello es preciso conservar al menos un 25 % de volumen esplénico remanente (15). En las series más antiguas, y si hay dudas de malignidad, se efectuaba más frecuentemente esplenectomía total. Las resecciones parciales se basan en la anatomía segmentaria del bazo y el punto más demandante técnicamente de las mismas es el control del potencial sangrado intraoperatorio.
En el postoperatorio se debe prevenir la sepsis mediante vacunación para neumococo, menigococo y hemophilus. También se deben prevenir con heparina fraccionada episodios de tromboembolias, incluidas las del eje portomesentérico, relacionados con la frecuente trombocitosis reactiva postesplenectomía. La otra complicación más importante son las fístulas pancreáticas.
Conclusiones
La SANT es una patología vascular esplénica inusual que afecta más frecuentemente a mujeres en la década de sus 50 años.
Dado que no existen criterios radiológicos definitivos para descartar una patología maligna, cuando se sospeche un caso de SANT la esplenectomía (total o parcial) es lo recomendado.
La biopsia por punción percutánea no es recomendable y la AP definitiva es la que permite certificar el diagnostico.
Declaraciones y conflictos de intereses: Los autores han revisado y dado su autorización para la publicación del artículo en la revista ACIRCAL. Asimismo, declaran no tener ningún conflicto de intereses, no haber sido presentado en reunión y/o congreso alguno, y que no está siendo evaluado por otra publicación científica de forma simultánea.
Referencias bibliográficas:
1- Martel M, Cheuk W, Lombardi L, Lifschitz-Mercer B, Chan J K C, Rosai J. Sclerosing angiomatoid nodular transformation (SANT): report of 25 cases of a distinctive benign splenic lesion. Am J Surg Pathol 2004; 28(10): 1268–1279
2- Koreishi AF, Saenz AJ, Fleming SE, Teruya-Feldstein J. Sclerosing Angiomatoid Nodular Transformation (SANT) of the spleen: a report of 3 cases. Int J Surg Pathol 2009; 17: 384-9
3- Martínez PJ, Solbes R, Bosquet C, Roig J. Transformación angiomatosa nodular esclerosante. Rev. esp. enferm. dig. 2017, vol 109 nº 3
4- Lado Lado F, Páramo de Vega M, Torre Carballada J, Lois Pernas A, Abdulkader I. Pseudotumor inflamatorio del bazo. Revisión y aportación de un nuevo caso. An. Med. Interna 2004 ; vol 21, 279-282
5- Aracil-León E, Olona-Casas C, Taco-Sánchez R, Raventós-Estellé A. Transformación nodular angiomatoide esclerosante (SANT) del bazo. Presentación de un caso y revisión de la literatura. Rev Esp Patol. Vol 49, Enero-Febrero 2016, 45-49
6- Jin Y, Hu H, Regmi P, Li F, Cheng N. Treatment options for sclerosing angiomatoid nodular transformation of spleen. HPB. 2020
7- Cao Z, Wang Q, Li J, Xu J, Li J. Multifocal sclerosing angiomatoid nodular transformation of the spleen: a case report and review of literatura. Diagnostic Pathology 2015, vol 10, nº 1, 95
8- Nájera L, Dotor AM, Santonja C. Angioma esplénico de células litorales. Descripción de un caso y revisión de la literatura. Rev Esp Patol 2006, vol.39, nº1: 49-53
9- Nagai Y, Satoh D, Matsukawa H, Shiozaki S. Sclerosing angiomatoid nodular transformation of the spleen presenting rapid growth after adrenalectomy: report of a case. Int J Surg Case Rep 2017; 30: 108–111
10- Kornprat P, Beham-Schmid C, Parvizi M, Portugaller H, Bernhardt G, Mischinger HJ. Incidental finding of sclerosing angiomatoid nodular transformation of the spleen. Wien Klin Wochenschr 2012, 124 (3-4), 100-103
11- Murthy V, Miller B, Nikolousis EM, Pratt G, Rudzki Z. Sclerosing angiomatoid nodular transformation of the spleen. Clin Case Rep. 2015 Oct; 3(10): 888–890
12- Kakisaka T, Kamiyama T, Yokoo H, et al. Hand-assisted laparoscopic splenectomy for sclerosing angiomatoid nodular transformation of the spleen complicated by chronic disseminated intravascular coagulation: a case report. Asian Journal of Endoscopic Surgery 2014; 7(3):275–278
13- Burneo M, Franco R, Castro Y, Pérez D, Turégano F. Transformación angiomatosa nodular esclerosante del bazo (SANT). Un tumor muy infrecuente. Cir Esp 2011; vol 90 (9 ), 607-609
14- Budzynski A, Demczuk S, Kumiega B, Migaczewski M, Matlok M, Zub-Pokrowiecka A. Sclerosing angiomatoid nodular transformation of the spleen treated by laparoscopic partial splenectomy. Videosurgery and Other Miniinvasive Techniques 2011; 6 (4): 249-255
15- Ramia J, De la Plaza Llamas, R, López-Marcano A, Valenzuela Torres J, García G J. Esplenectomía parcial laparoscópica por quiste epidermoide esplénico. Cir Esp 2017, vol 95, 613-615.